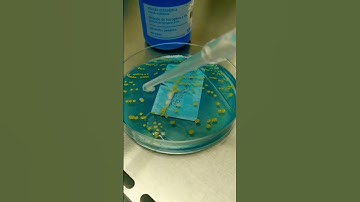
#microbiology #viral #video #youtubeshorts #trendingshorts #shorts #biology

⬇ DOWNLOAD NOW
Kalau muncul iklan pop-up, tutup lalu klik tombol kembali
Download lagu Metatranscriptomics: Unveiling Microbial Life & Activity #bioinformatics #shorts #shortvideo #viral secara gratis hanya untuk keperluan promosi. Dukung artis favorit kamu dengan membeli musik original di iTunes atau platform resmi lainnya.
 Metatranscriptomics tutorial Part 1/2 #education #shorts #shortvideo #viralvideo #videos #videoviral
Metatranscriptomics tutorial Part 1/2 #education #shorts #shortvideo #viralvideo #videos #videoviral
 dust in our nails in microscope view #shorts #microscope #nails #germs
dust in our nails in microscope view #shorts #microscope #nails #germs
 Pond Water Under Microscope | TULO - Microscope #shorts #protozoa #biology
Pond Water Under Microscope | TULO - Microscope #shorts #protozoa #biology
 Microbes in the nails: microorganisms effects 2021
Microbes in the nails: microorganisms effects 2021
 The Unseen Architects of Evolution
The Unseen Architects of Evolution
#microbiology #viral #video #youtubeshorts #trendingshorts #shorts #biology
#microbiology #viral #video #youtubeshorts #trendingshorts #shorts #biology
 Life inside us #facts #shorts #microbiology
Life inside us #facts #shorts #microbiology
 What Is Metagenomics? | Unlocking the Hidden World of Microbes 🧬 in 60 seconds
What Is Metagenomics? | Unlocking the Hidden World of Microbes 🧬 in 60 seconds